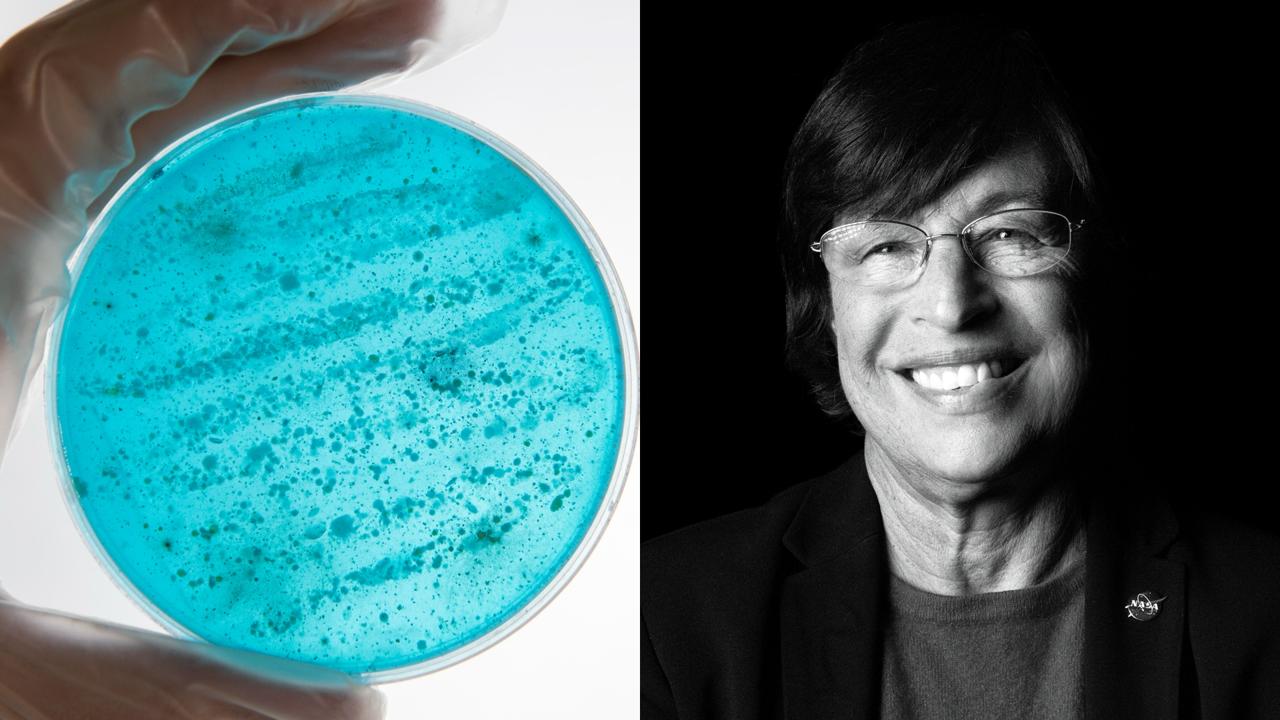

Lynn Rothschild
Nature’s Hardware Store
Recorded live on Oct 14, 02025
at Cowell Theater in Fort Mason Center
What if the solutions to humanity's greatest challenges — on Earth and beyond — have already been invented by nature?
While engineers and designers in traditional fields have often tried to invent novel technological tools that transcend the natural capacities of life on this planet, another group of scientists and innovators have turned instead to those natural capacities themselves, drawing on examples from across the myriad shapes that life takes on our planet in order to find creative models for complex problem-solving. One of the foremost researchers in this field is Dr. Lynn J. Rothschild of NASA's Ames Research Center, who has used her expertise across molecular biology, evolutionary biology and phycology to help explore the bleeding edge of synthetic biology.
In her Long Now Talk, Dr. Rothschild will open the doors to "Nature's hardware store" — a vast, largely untapped reservoir of biological strategies available to scientists, engineers, and innovators. Dr. Rothschild's own work in recent years has included 3D-printing trees, designing fungal-based housing fit for the moon, and building synthetic cells de novo in the lab. In doing so, she has connected theoretical insights about the very nature of life on this planet with practical applications and future directions for innovation on the hardest problems facing our civilization.
About Lynn J. Rothschild
Dr. Lynn J. Rothschild is a research scientist at NASA Ames and Adjunct Professor at Brown University and Stanford University working in astrobiology, evolutionary biology and synthetic biology. Rothschild's work focuses on the origin and evolution of life on Earth and in space, and in pioneering the use of synthetic biology to enable space exploration.
From 02011 through 02019 Rothschild served as the faculty advisor of the award-winning Stanford-Brown iGEM (international Genetically Engineered Machine Competition) team, exploring innovative technologies such as biomining, mycotecture, BioWires, making a biodegradable UAS (drone) and an astropharmacy. Rothschild is a past president of the Society of Protozoologists, fellow of the Linnean Society of London, The California Academy of Sciences and the Explorer's Club and lectures and speaks about her work widely.
Why This Talk Matters Now
In the crux of our present moment, as global changes in our biosphere shift the conditions of life on our planet towards increasing inhospitality and the dream of interplanetary travel continues to captivate many, it seems all the more vital to seek design solutions to these challenges in even the most unexpected avenues. To recognize in the diversity of biological life both parallels to our own problems and paths to potential answers is to find a key insight that we would be foolish to ignore.
The Long View
Synthetic biology is one mode of long-term thinking in practice. By drawing on the deep knowledge of nature, designed by evolutionary processes over the course of millions or even billions of years, we can more capably address even the novel problems of extraplanetary travel and settlement. In 02014, Dr. Drew J. Endy gave a Long Now Talk on the iGEM Revolution, which discussed the potentials of intentionally genetically engineered machines to benefit humanity in unexpected ways. Likewise, NASA astrobiologist David Grinspoon gave a 02017 Long Now Talk in which he argued that the history of the biological re-shaping of planet Earth provides a roadmap for how we might approach our responsibilities to our planet in the anthropocene.
Learn More
Read a 02020 interview with Dr. Lynn Rothschild from NASA.
Read a 02024 perspectives paper from Dr. Lynn Rothschild on making synthetic cells in ACS Synthetic Biology
Watch Dr. Lynn Rothschild's 02019 TED Talk on space exploration and synthetic biology.
watch
bio
Lynn J. Rothschild is a research scientist at NASA Ames and Adjunct Professor at Brown University and Stanford University working in astrobiology, evolutionary biology and synthetic biology. Rothschild's work focuses on the origin and evolution of life on Earth and in space, and in pioneering the use of synthetic biology to enable space exploration.
From 2011 through 2019 Rothschild served as the faculty advisor of the award-winning Stanford-Brown iGEM (international Genetically Engineered Machine Competition) team, exploring innovative technologies such as biomining, mycotecture, BioWires, making a biodegradable UAS (drone) and an astropharmacy. Rothschild is a past-president of the Society of Protozoologists, fellow of the Linnean Society of London, The California Academy of Sciences and the Explorer’s Club and lectures and speaks about her work widely.
Join our newsletter for the latest in long-term thinking
Subscribe